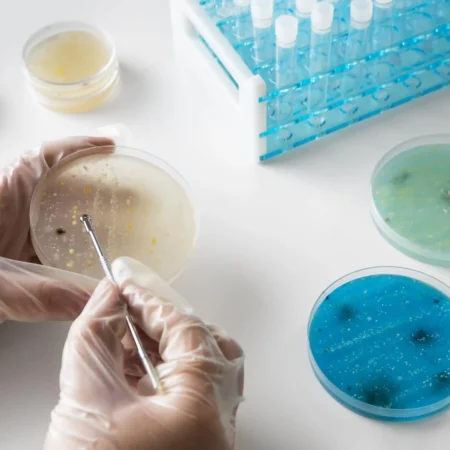
Curso de Análisis e Identificación de Microplásticos en Laboratorio 1

Ingeniería y tecnología
-
Curso de Análisis e Identificación de Microplásticos en Laboratorio
-

Curso de Comunicación Ambiental y Estrategias de Educación sobre Microplásticos
-

Curso de Diseño y Optimización de Cimentaciones
-

Curso de Evaluación de Riesgo Toxicológico por Microplásticos en Humanos
-

Curso de Geoingeniería Aplicada a Proyectos de Infraestructura
-

Curso en Ingeniería de Filtración y Control de Microplásticos
-

Curso sobre Gestión de Proyectos en Geoingeniería
-

Curso sobre Prospección Geofísica Aplicada a la Geoingeniería
-

Diplomado en Economía Circular y Reducción de Microplásticos
